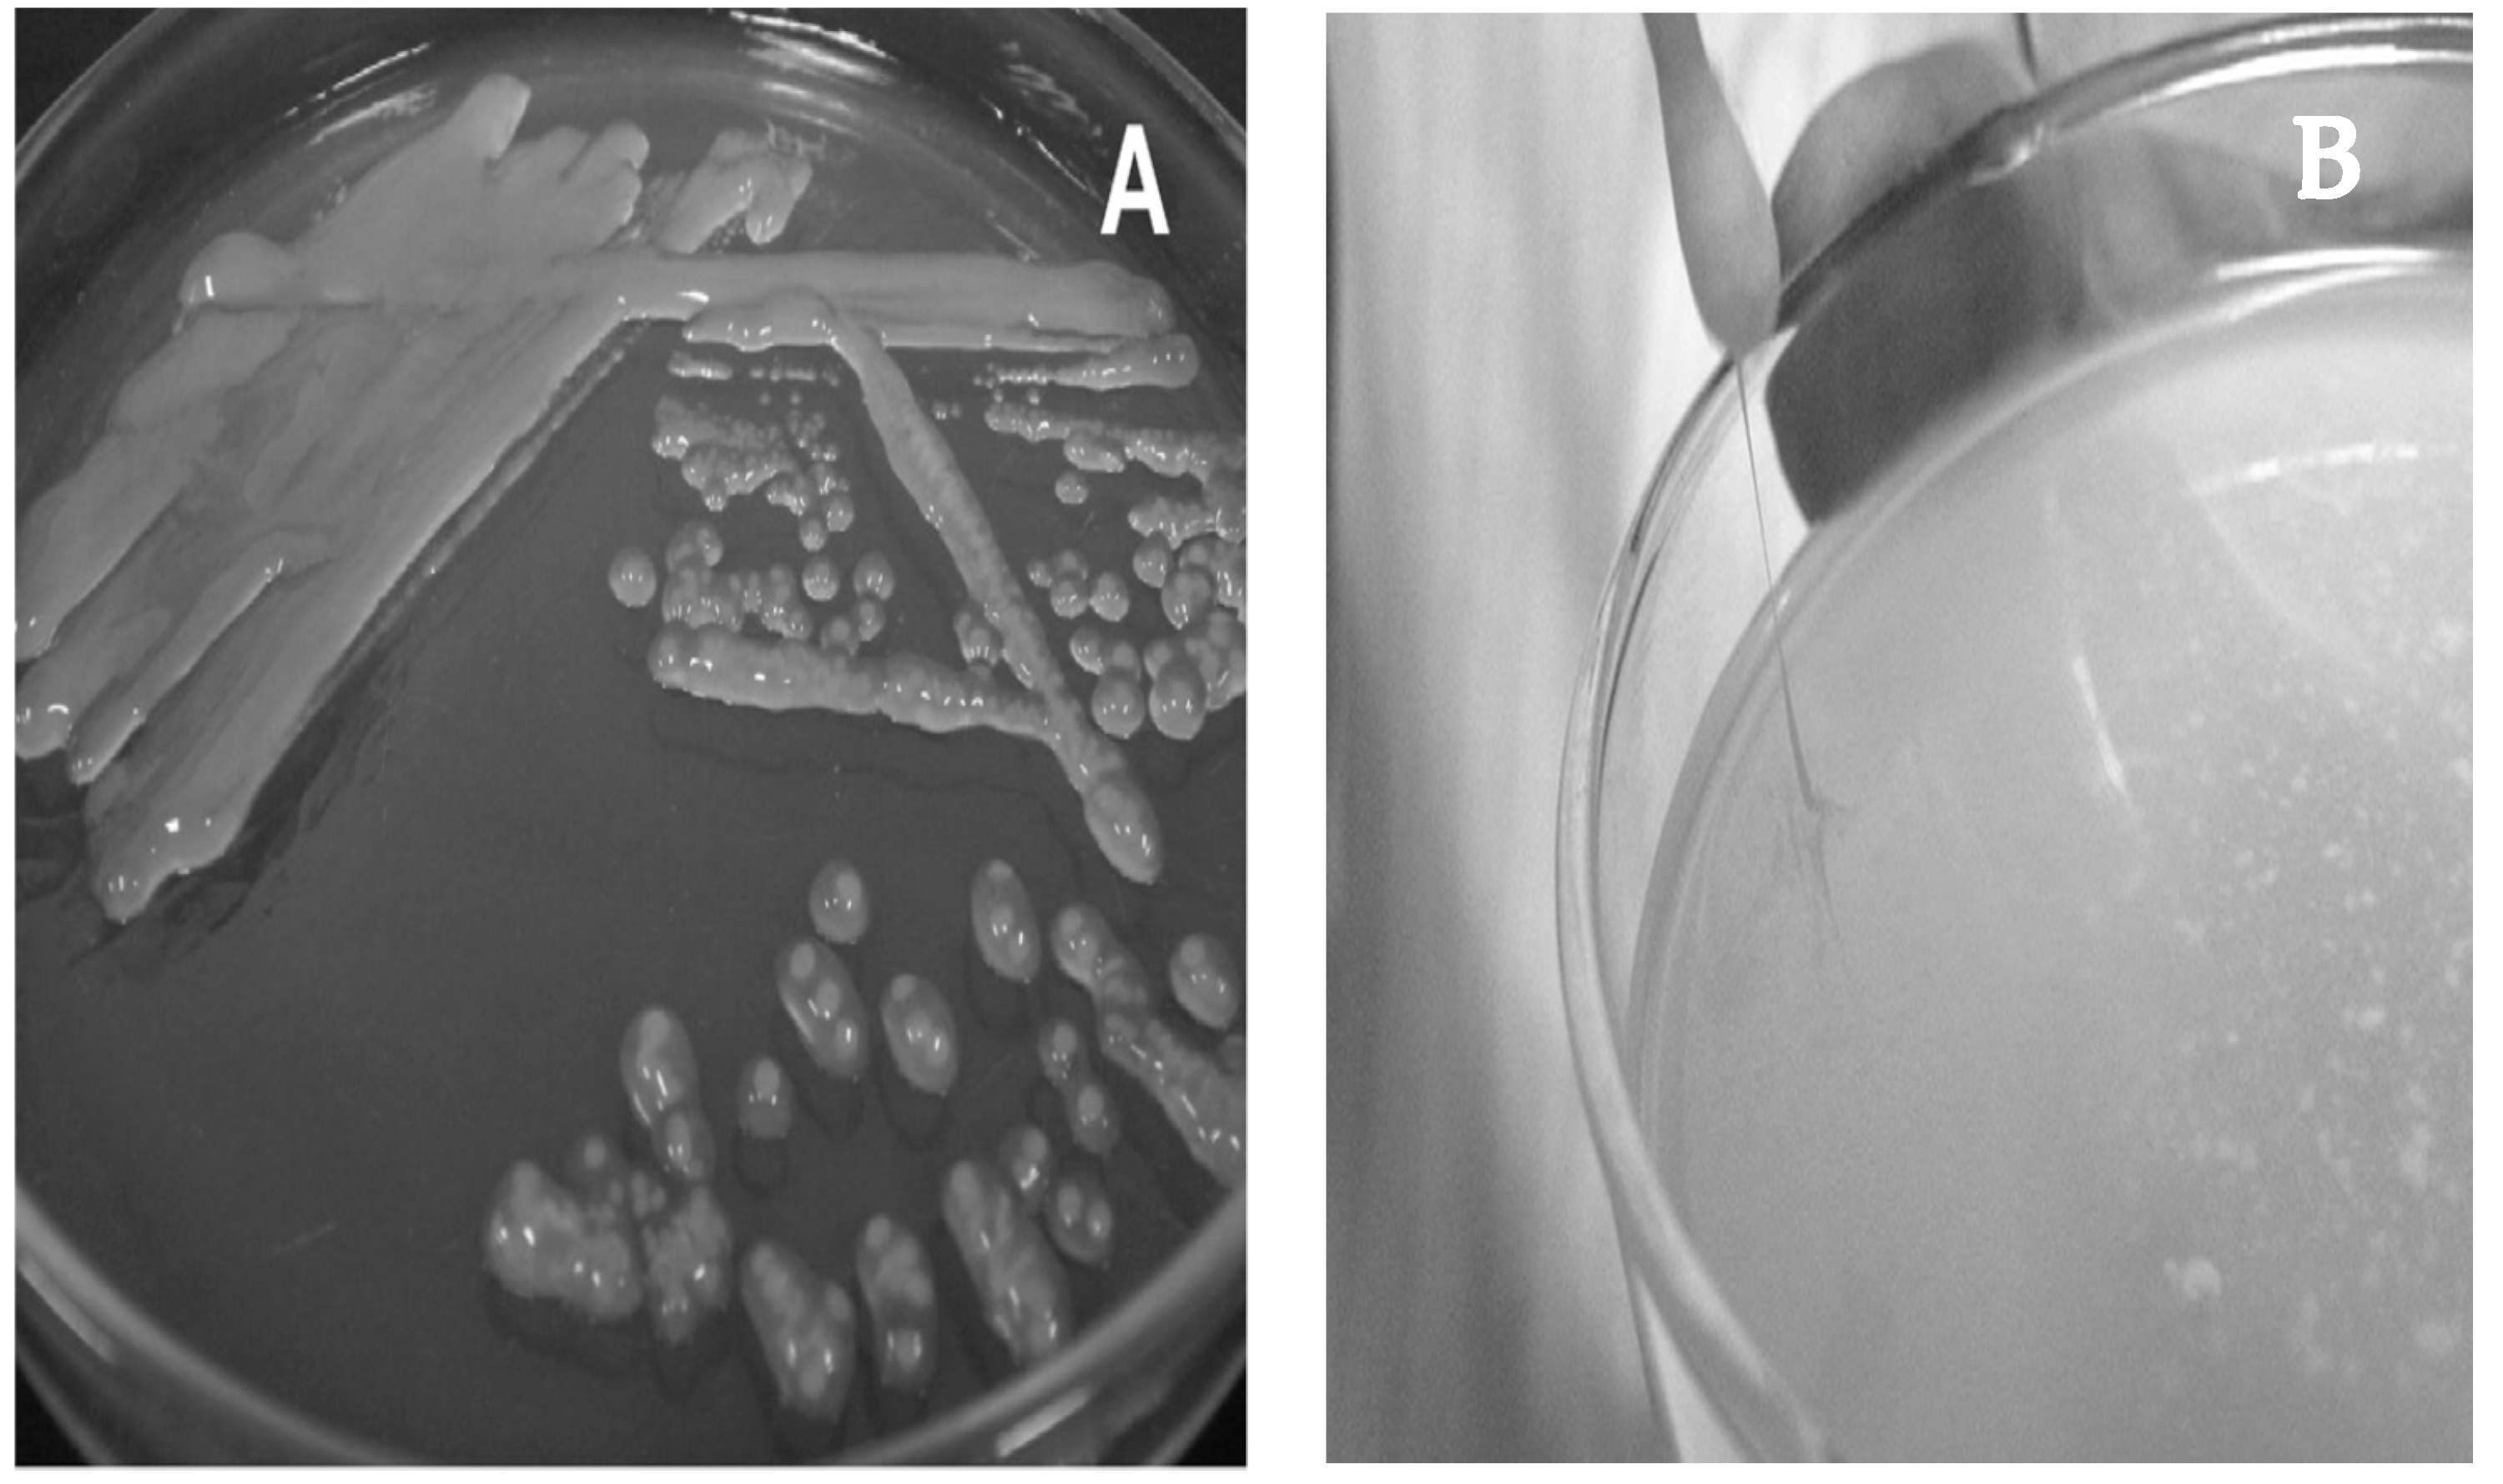
Microorganisms 09 02158 g002

Lactobacillus kefiranofaciens: From Isolation and Taxonomy to Probiotic Properties and Applications
Abstract
1. Introduction
2. A Brief Isolation and Taxonomic History
3. Isolation and Growth Conditions
4. Biochemical and Physiological Characteristics
5. Species and Subspecies Discrimination
5.1. Culture-Dependent Approaches
5.2. Discrimination at the Subspecies Level
5.3. Culture-Independent Approaches
5.4. High-Throughput Sequencing, Metabolomics and Transcriptomics
6. Ecological Niches
7. EPS Production–Kefiran
7.1. Kefiran Production and Purification
7.2. Kefiran Chemical Structure
7.3. Genomics Studies
7.4. Applications
8. Safety Status of L. kefiranofaciens
9. Functional and Probiotic Properties of L. kefiranofaciens
9.1. Antimicrobial Activity
9.2. Immunomodulatory Action
9.3. Role in Metabolic Disorders
9.4. Gut Microbiota Modulation
9.5. Other Health-Promoting Properties
9.6. Health-Promoting Properties of Fermentation Products or Metabolites
9.7. Genomics for Probiotic-Associated Traits
9.8. L. kefiranofaciens Patent
10. Functional Properties of Kefiran
10.1. Antimicrobial Activity
10.2. Immunomodulatory Action
10.3. Beneficial Effects on Diseases
10.4. Antitumor Activity
10.5. Gut Microbiota Modulation
10.6. Other Properties
11. Use in Dairy Products
11.1. Production of Kefir Grains and Beverages Containing L. kefiranofaciens
11.2. Cheese Production Containing L. kefiranofaciens
11.3. Other Products
12. Conclusions
Author Contributions
Funding
Acknowledgments
Conflicts of Interest
References
- Kabak, B.; Dobson, A.D. An introduction to the traditional fermented foods and beverages of Turkey. Crit. Rev. Food Sci. Nutr. 2011, 51, 248–260. [Google Scholar] [CrossRef]
- Kandler, O.; Kunath, P. Lactobacillus kefir sp. nov., a component of the microflora of Kefir. Syst. Appl. Microbiol. 1983, 4, 286–294. [Google Scholar] [CrossRef]
- Fujisawa, T.; Adachi, S.; Toba, T.; Arihara, K.; Mitsuoka, T. Lactobacillus kefiranofaciens sp. nov. isolated from kefir grains. Int. J. Syst. Bacteriol. 1988, 38, 12–14. [Google Scholar] [CrossRef]
- Takizawa, S.; Kojima, S.; Tamura, S.; Fujinaga, S.; Benno, Y.; Nakase, T. Lactobacillus kefirgranum sp. nov. and Lactobacillus parakefir sp. nov., two new species from kefir grains. Int. J. Syst. Bacteriol. 1994, 44, 435–439. [Google Scholar] [CrossRef]
- EFSA. Update of the list of Qps-recommended biological agents intentionally added to food or feed as notified to EFSA 4: Suitability of taxonomic units notified to EFSA until March 2016. EFSA J. 2016, 14, e04522. [Google Scholar]
- Hill, D.; Sugrue, I.; Tobin, C.; Hill, C.; Stanton, C.; Ross, R.P. The Lactobacillus casei Group: History and Health Related Applications. Front. Microbiol. 2018, 9, 2107. [Google Scholar] [CrossRef]
- Rossi, F.; Amadoro, C.; Colavita, G. Members of the Lactobacillus Genus Complex (LGC) as Opportunistic Pathogens: A Review. Microorganisms 2019, 7, 126. [Google Scholar] [CrossRef]
- Zheng, J.; Wittouck, S.; Salvetti, E.; Franz, C.M.A.P.; Harris, H.M.B.; Mattarelli, P.; O’Toole, P.W.; Pot, B.; Vandamme, P.; Walter, J.; et al. A taxonomic note on the genus Lactobacillus: Description of 23 novel genera, emended description of the genus Lactobacillus Beijerinck 1901, and union of Lactobacillaceae and Leuconostocaceae. Int. J. Syst. Evol. Microbiol. 2020, 70, 2782–2858. [Google Scholar] [CrossRef]
- De Melo Pereira, G.V.; de Carvalho Neto, D.P.; Maske, B.L.; De Dea Lindner, J.; Vale, A.S.; Favero, G.R.; Viesser, J.; de Carvalho, J.C.; Góes-Neto, A.; Soccol, C.R. An updated review on bacterial community composition of traditional fermented milk products: What next-generation sequencing has revealed so far? Crit. Rev. Food Sci. Nutr. 2020, 1–20. [Google Scholar] [CrossRef]
- Vancanneyt, M.; Mengaud, J.; Cleenwerck, I.; Vanhonacker, K.; Hoste, B. Reclassification of Lactobacillus kefirgranum Takizawa et al. 1994 as Lactobacillus kefiranofaciens subsp. kefirgranum subsp. nov. and emended description of L. kefiranofaciens Fujisawa et al. 1988. Int. J. Syst. Evol. Microbiol. 2004, 54, 551–556. [Google Scholar] [CrossRef]
- Rivière, J.W.M.; Kooiman, P.; Schmidt, K. Kefiran, a novel polysaccharide produced in the kefir grain by Lactobacillus brevis. Arch. Mikrobiol. 1967, 59, 269–278. [Google Scholar] [CrossRef] [PubMed]
- Toba, T.; Abe, S.; Arihara, K.; Adachi, S. A medium for the isolation of capsular bacteria from kefir grains. Agric. Biol. Chem. 1986, 50, 2673–2674. [Google Scholar] [CrossRef]
- Wang, Y.; Wang, J.; Ahmed, Z.; Bai, X.; Wang, J. Complete genome sequence of Lactobacillus kefiranofaciens ZW3. J. Bacteriol. 2011, 193, 4280–4281. [Google Scholar] [CrossRef] [PubMed]
- Carver, T.; Thomson, N.; Bleasby, A.; Berriman, M.; Parkhill, J. DNAPlotter: Circular and linear interactive genome visualization. Bioinformatics 2009, 25, 119–120. [Google Scholar] [CrossRef]
- Toba, T.; Abe, S.; Adachi, S. Modification of KPL medium for polysaccharide production by Lactobacillus sp. isolated from kefir grain. Jpn. J. Zootech. Sci. 1987, 58, 987–990. [Google Scholar] [CrossRef]
- Mitsuoka, T. Vergleichende Untersuchungen über die Laktobazillen aus den Faeces von Menschen, Schweinen und Hiihnern. Zentralbl. Bakteriol. Parsitenkd. Infektionskr. Hyg. Abt. 1969, 210, 32–51. [Google Scholar]
- Mitsuoka, T.; Sega, T.; Yamamoto, S. Eine verbesserte Methodik der qualitativen und quantativen Analyse der Darm flora von Menschen und Tieren. Zentralbl. Bakteriol. Parasitenkd. Infektionskr. Hyg. Abt. 1964, 195, 445–469. [Google Scholar]
- Mainville, I.; Robert, N.; Lee, B.; Farnworth, E.R. Polyphasic characterization of the lactic acid bacteria in kefir. Syst. Appl. Microbiol. 2006, 29, 59–68. [Google Scholar] [CrossRef]
- Kojima, S.; Takizawa, S.; Tamura, S.; Fujinaga, S.; Benno, Y.; Nakase, T. An improved medium for the isolation of lactobacilli from kefir grains. Biosci. Biotechnol. Biochem. 1993, 57, 119–120. [Google Scholar] [CrossRef]
- Lemieux, P.; Precourt, L.P.; Simard, E. Use of Lactobacillus kefiranofaciens as a Probiotic and a Symbiotic. Patent Pub. No. WO2006084381A1, 17 August 2006. [Google Scholar]
- Wang, Y.P.; Ahmed, Z.; Feng, W.; Li, C.; Song, S.Y. Physicochemical properties of exopolysaccharide produced by Lactobacillus kefiranofaciens ZW3 isolated from Tibet kefir. Int. J. Biol. Macromol. 2008, 43, 283–288. [Google Scholar] [CrossRef]
- Zanirati, D.F.; Abatemarco, M.; de CiccoSandes, S.H.; Nicoli, J.R.; Nunes, Á.C.; Neumann, E. Selection of lactic acid bacteria from Brazilian kefir grains for potential use as starter or probiotic cultures. Anaerobe 2015, 32, 70–76. [Google Scholar] [CrossRef]
- Garofalo, C.; Osimani, A.; Milanovic, V.; Aquilanti, L.; De Filippis, F.; Stellato, G.; Di Mauro, S.; Turchetti, B.; Buzzini, P.; Ercolini, D.; et al. Bacteria and yeast microbiota in milk kefir grains from different Italian regions. Food Microbiol. 2015, 49, 123–133. [Google Scholar] [CrossRef]
- Garrote, G.L.; Abraham, A.G.; De Antoni, G.L. Chemical and microbiological characterisation of kefir grains. J. Dairy Res. 2001, 68, 639–652. [Google Scholar] [CrossRef] [PubMed]
- Simova, E.; Beshkova, D.; Angelov, A.; Hristozova, T.; Frengova, G.; Spasov, Z. Lactic acid bacteria and yeasts in kefir grains and kefir made from them. J. Ind. Microbiol. Biotechnol. 2002, 28, 1–6. [Google Scholar] [CrossRef] [PubMed]
- Chen, H.C.; Wang, S.Y.; Chen, M.J. Microbiological study of lactic acid bacteria in kefir grains by culture-dependent and culture-independent methods. Food Microbiol. 2008, 25, 492–501. [Google Scholar] [CrossRef]
- Hamet, M.F.; Londero, A.; Medrano, M.; Vercammen, E.; Van Hoorde, K.; Garrote, G.L.; Huys, G.; Vandamme, P.; Abraham, A.G. Application of culture-dependent and culture independent methods for the identification of Lactobacillus kefiranofaciens in microbial consortia present in kefir grains. Food Microbiol. 2013, 36, 327–334. [Google Scholar] [CrossRef] [PubMed]
- Wang, X.; Xiao, J.; Jia, Y.; Pan, Y.; Wang, Y. Lactobacillus kefiranofaciens, the sole dominant and stable bacterial species, exhibits distinct morphotypes upon colonization in Tibetan kefir grains. Heliyon 2018, 4, e00649. [Google Scholar] [CrossRef]
- Kesmen, Z.; Kacmaz, N. Determination of lactic microflora of kefir grains and kefir beverage by using culture-dependent and culture-independent methods. J. Food Sci. 2011, 76, 276–283. [Google Scholar] [CrossRef]
- Kotova, I.B.; Cherdyntseva, T.A.; Netrusov, A.I. Russian kefir grains microbial composition and its changes during production process. Adv. Exp. Med. Biol. 2016, 932, 93–121. [Google Scholar] [CrossRef]
- Dobson, A.; O’Sullivan, O.; Cotter, P.D.; Ross, P.; Hill, C. High-throughput sequence-based analysis of the bacterial composition of kefir and an associated kefir grain. FEMS Microbiol. Lett. 2011, 320, 56–62. [Google Scholar] [CrossRef]
- Blasche, S.; Kim, Y.; Mars, R.A.T.; Machado, D.; Maansson, M.; Kafkia, E.; Milanese, A.; Zeller, G.; Teusink, B.; Nielsen, J.; et al. Metabolic cooperation and spatiotemporal niche partitioning in a kefir microbial community. Nat. Microbiol. 2021, 6, 196–208. [Google Scholar] [CrossRef]
- Paiva, I.M.D.; Steinberg, R.D.S.; Lula, I.S.; Souza-Fagundes, E.M.D.; Mendes, T.D.O.; Bell, M.J.V.; Nicoli, J.R.; Nunes, T.C.; Neumann, E. Lactobacillus kefiranofaciens and Lactobacillus satsumensis isolated from Brazilian kefir grains produce alpha-glucans that are potentially suitable for food applications. LWT 2016, 72, 390–398. [Google Scholar] [CrossRef]
- Walsh, A.M.; Crispie, F.; Kilcawley, K.; O’Sullivan, O.; O’Sullivan, M.G.; Claesson, M.J.; Cotter, P.D. Microbial Succession and Flavor Production in the Fermented Dairy Beverage Kefir. mSystems 2016, 1, e00052-16. [Google Scholar] [CrossRef] [PubMed]
- Dertli, E.; Çon, A.H. Microbial diversity of traditional kefir grains and their role on kefir aroma. LWT 2017, 85, 151–157. [Google Scholar] [CrossRef]
- Bengoa, A.A.; Iraporda, C.; Garrote, G.L.; Abraham, A.G. Kefir micro-organisms: Their role in grain assembly and health properties of fermented milk. J. Appl. Microbiol. 2018, 126, 686–700. [Google Scholar] [CrossRef]
- Kim, D.H.; Chon, J.W.; Kim, H.S.; Yim, J.H.; Kim, H.; Seo, K.H. Rapid Detection of Lactobacillus kefiranofaciens in Kefir Grain and Kefir Milk Using Newly Developed Real-Time PCR. J. Food Prot. 2015, 78, 855–858. [Google Scholar] [CrossRef] [PubMed]
- Nejati, F.; Junne, S.; Kurreck, J.; Neubauer, P. Quantification of Major Bacteria and Yeast Species in Kefir Consortia by Multiplex TaqMan qPCR. Front. Microbiol. 2020, 11, 1291. [Google Scholar] [CrossRef] [PubMed]
- Takizawa, S.; Kojima, S.; Tamura, S.; Fujinaga, S.; Benno, Y.; Nakase, T. The composition of the Lactobacillus flora in kefir grains. Syst. Appl. Microbiol. 1998, 21, 121–127. [Google Scholar] [CrossRef]
- Kojic, M.; Vujcic, M.; Banina, A.; Cocconcelli, P.; Cerning, J.; Topisirovic, L. Analysis of exopolysaccharide production by Lactobacillus casei CG11, isolated from cheese. Appl. Environ. Microbiol. 1992, 58, 4086–4088. [Google Scholar] [CrossRef] [PubMed]
- Vescovo, M.; Scolari, G.L.; Bottazzi, V. Plasmid-encoded ropiness production in Lactobacillus casei ssp. casei. Biotechnol. Lett. 1989, 11, 709–712. [Google Scholar] [CrossRef]
- Bosch, A.; Golowczyc, M.A.; Abraham, A.G.; Garrote, G.L.; De Antoni, G.L.; Yantorno, O. Rapid discrimination of lactobacilli isolated from kefir grains by FT-IR spectroscopy. Int. J. Food Microbiol. 2006, 111, 280–287. [Google Scholar] [CrossRef] [PubMed]
- Boot, H.J.; Kolen, C.P.A.M.; Pot, B.; Kersters, K.; Pouwels, P.H. The presence of two S-layer-protein-encoding genes is conserved among species related to Lactobacillus acidophilus. Microbiology 1996, 142, 2375–2384. [Google Scholar] [CrossRef] [PubMed][Green Version]
- Gao, W.; Zhang, L.; Feng, Z.; Liu, H.; Shigwedha, N.; Han, X.; Yi, H.; Liu, W.; Zhang, S. Microbial diversity and stability during primary cultivation and subcultivation processes of Tibetan kefir. Int. J. Food Sci. Technol. 2015, 50, 1468–1476. [Google Scholar] [CrossRef]
- Zhou, J.; Liu, X.; Jiang, H.; Dong, M. Analysis of the microflora in Tibetan kefir grains using denaturing gradient gel electrophoresis. Food Microbiol. 2009, 26, 770–775. [Google Scholar] [CrossRef]
- Leite, A.M.O.; Mayoa, B.; Rachid, C.T.; Peixoto, R.S.; Silva, J.T.; Paschoalin, V.M.; Delgado, S. Assessment of the microbial diversity of Brazilian kefir grains by PCR-DGGE and pyrosequencing analysis. Food Microbiol. 2012, 31, 215–221. [Google Scholar] [CrossRef]
- Magalhães, K.T.; Pereira, M.A.; Nicolau, A.; Dragone, G.; Domingues, L.; Teixeira, J.A.; Silva, J.B.A.; Schwan, R.F. Production of fermented cheese whey-based beverage using kefir grains as starter culture: Evaluation of morphological and microbial variations. Bioresour. Technol. 2010, 101, 8843–8850. [Google Scholar] [CrossRef]
- Vardjan, T.; Mohar Lorbeg, P.; Rogelj, I.; Čanžek Majhenič, A. Characterization and stability of lactobacilli and yeast microbiota in kefir grains. J. Dairy Sci. 2013, 96, 2729–2736. [Google Scholar] [CrossRef]
- Ninane, V.; Mukandayambaje, R.; Berben, G. Identification of lactic acid bacteria within the consortium of a kefir grain by sequencing 16S rDNA variable regions. J. AOAC Int. 2007, 90, 1111–1117. [Google Scholar] [CrossRef]
- Korsak, N.; Taminiau, B.; Leclercq, M.; Nezer, C.; Crevecoeur, S.; Ferauche, C.; Detry, E.; Delcenserie, V.; Daube, G. Short communication: Evaluation of the microbiota of kefir samples using metagenetic analysis targeting the 16S and 26S ribosomal DNA fragments. J. Dairy Sci. 2015, 98, 3684–3689. [Google Scholar] [CrossRef]
- Nalbantoglu, U.; Cakar, A.; Dogan, H.; Abaci, N.; Ustek, D.; Sayood, K.; Can, H. Metagenomic analysis of the microbial community in kefir grains. Food Microbiol. 2014, 41, 42–51. [Google Scholar] [CrossRef]
- Bourrie, B.C.T.; Willing, B.P.; Cotter, P.D. The Microbiota and Health Promoting Characteristics of the Fermented Beverage Kefir. Front. Microbiol. 2016, 7, 647. [Google Scholar] [CrossRef] [PubMed]
- Wang, Z.; Gerstein, M.; Snyder, M. RNA-Seq: A revolutionary tool for transcriptomics. Nat. Rev. Genet. 2009, 10, 57–63. [Google Scholar] [CrossRef] [PubMed]
- Wang, S.Y.; Chen, K.N.; Lo, Y.M.; Chiang, M.L.; Chen, H.C.; Liu, J.R.; Chen, M.J. Investigation of microorganisms involved in biosynthesis of the kefir grain. Food Microbiol. 2012, 32, 274–285. [Google Scholar] [CrossRef] [PubMed]
- Taş, T.K.; Ekinci, F.Y.; Guzel-Seydim, Z.B. Identification of microbial flora in kefir grains produced in Turkey using PCR. Int. J. Dairy Technol. 2011, 65, 126–131. [Google Scholar] [CrossRef]
- Dallas, D.C.; Citerne, F.; Tian, T.; Silva, V.L.M.; Kalanetra, K.M.; Frese, S.A.; Robinson, R.C.; Mills, D.A.; Barile, D. Peptidomic analysis reveals proteolytic activity of kefir microorganisms on bovine milk proteins. Food Chem. 2016, 197, 273–284. [Google Scholar] [CrossRef]
- Zamberi, N.R.; Mohamad, N.E.; Yeap, S.K.; Ky, H.; Beh, B.K.; Liew, W.C.; Tan, S.W.; Ho, W.Y.; Boo, S.Y.; Chua, Y.H.; et al. 16S Metagenomic Microbial Composition Analysis of Kefir Grain using MEGAN and BaseSpace. Food Biotechnol. 2016, 30, 219–230. [Google Scholar] [CrossRef]
- Gao, W.; Zhang, L. Comparative analysis of the microbial community composition between Tibetan kefir grains and milks. Food Res. Int. 2019, 116, 137–144. [Google Scholar] [CrossRef]
- Hong, J.-Y.; Lee, N.-K.; Yi, S.-H.; Hong, S.-P.; Paik, H.-D. Short communication: Physicochemical features and microbial community of milk kefir using a potential probiotic Saccharomyces cerevisiae KU200284. J. Dairy Sci. 2019, 102, 10845–10849. [Google Scholar] [CrossRef] [PubMed]
- Liu, W.; Zhang, M.; Xie, J.; Wang, H.; Zhao, X.; Chen, B.; Suo, H. Comparative analyses of microbial community diversities of Tibetan kefir grains from three geographic regions. Int. J. Dairy Technol. 2019, 72, 536–544. [Google Scholar] [CrossRef]
- Purutoğlu, K.; İspirli, H.; Yüzer, M.O.; Serencam, H.; Dertli, E. Diversity and functional characteristics of lactic acid bacteria from traditional kefir grains. Int. J. Dairy Technol. 2019, 73, 57–66. [Google Scholar] [CrossRef]
- Kalamaki, M.S.; Angelidis, A.S. High-Throughput, Sequence-Based Analysis of the Microbiota of Greek Kefir Grains from Two Geographic Regions. Food Technol. Biotechnol. 2020, 58, 138–146. [Google Scholar] [CrossRef] [PubMed]
- Kim, D.H.; Kim, H.; Seo, K.H. Microbial composition of Korean kefir and antimicrobial activity of Acetobacter fabarum DH1801. J. Food Saf. 2020, 40, e12728. [Google Scholar] [CrossRef]
- Sindi, A.; Badsha, M.B.; Ünlü, G. Bacterial Populations in International Artisanal Kefirs. Microorganisms 2020, 8, 1318. [Google Scholar] [CrossRef] [PubMed]
- Wang, H.; Wang, C.; Guo, M. Autogenic successions of bacteria and fungi in kefir grains from different origins when sub-cultured in goat milk. Food Res. Int. 2020, 138, 109784. [Google Scholar] [CrossRef] [PubMed]
- Du, G.; Liu, L.; Guo, Q.; Cui, Y.; Chen, H.; Yuan, Y.; Wang, Z.; Gao, Z.; Sheng, Q.; Yue, T. Microbial community diversity associated with Tibetan kefir grains and its detoxification of Ochratoxin A during fermentation. Food Microbiol. 2021, 99, 103803. [Google Scholar] [CrossRef] [PubMed]
- Nejati, F.; Junne, S.; Neubauer, P.A. Big World in Small Grain: A Review of Natural Milk Kefir Starters. Microorganisms 2020, 8, 192. [Google Scholar] [CrossRef] [PubMed]
- Kazou, M.; Grafakou, A.; Tsakalidou, E.; Georgalaki, M. Zooming into the microbiota of home-made and industrial kefir produced in Greece using classical microbiological and amplicon-based metagenomics analyses. Front. Microbiol. 2021, 12, 621069. [Google Scholar] [CrossRef]
- Johnson, J.S.; Spakowicz, D.J.; Hong, B.; Petersen, L.M.; Demkowicz, P.; Chen, L.; Leopold, S.R.; Hanson, B.M.; Agresta, H.O.; Gerstein, M.; et al. Evaluation of 16S rRNA gene sequencing for species and strain-level microbiome analysis. Nat. Commun. 2019, 10, 5029. [Google Scholar] [CrossRef]
- Yu, B.; Miyamoto, T. Microflora in traditional starter cultures for fermented milk, hurunge, from Inner Mongolia, China. Anim. Sci. J. 2006, 77, 235–241. [Google Scholar] [CrossRef]
- Wu, R.; Wang, L.; Wang, J.; Li, H.; Menghe, B.; Wu, J.; Guo, M.; Zhang, H. Isolation and preliminary probiotic selection of lactobacilli from koumiss in Inner Mongolia. J. Basic Microbiol. 2009, 49, 318–326. [Google Scholar] [CrossRef]
- Sun, Z.; Liu, W.; Zhang, J.; Yu, J.; Zhang, W.; Cai, C.; Menghe, B.; Sun, T.; Zhang, H. Identification and characterization of the dominant lactobacilli isolated from koumiss in China. J. Gen. Appl. Microbiol. 2010, 56, 257–265. [Google Scholar] [CrossRef] [PubMed][Green Version]
- Watanabe, K.; Fujimoto, J.; Sasamoto, M.; Dugersuren, J.; Tumursuh, T.; Demberel, S. Diversity of lactic acid bacteria and yeasts in Airag and Tarag, traditional fermented milk products of Mongolia. World J. Microbiol. Biotechnol. 2007, 24, 1313–1325. [Google Scholar] [CrossRef]
- Hao, Y.; Zhao, L.; Zhang, H.; Zhai, Z.; Huang, Y.; Liu, X.; Zhang, L. Identification of the bacterial biodiversity in koumiss by denaturing gradient gel electrophoresis and species-specific polymerase chain reaction. J. Dairy Sci. 2010, 93, 1926–1933. [Google Scholar] [CrossRef] [PubMed]
- Zhang, M.; Dang, N.; Ren, D.; Zhao, F.; Lv, R.; Ma, T.; Bao, Q.; Menghe, B.; Liu, W. Comparison of Bacterial Microbiota in Raw Mare’s Milk and Koumiss Using PacBio Single Molecule Real-Time Sequencing Technology. Front Microbiol. 2020, 11, 581610. [Google Scholar] [CrossRef]
- Xu, H.; Liu, W.; Gesudu, Q.; Sun, Z.; Zhang, J.; Guo, Z.; Zheng, Y.; Hou, Q.; Yu, J.; Qing, Y.; et al. Assessment of the bacterial and fungal diversity in home-made yoghurts of Xinjiang, China by pyrosequencing. J. Sci. Food Agric. 2014, 95, 2007–2015. [Google Scholar] [CrossRef]
- Oki, K.; Dugersure, J.; Demberel, S.; Watanabe, K. Pyrosequencing Analysis of the Microbial Diversity of Airag, Khoormog and Tarag, Traditional Fermented Dairy Products of Mongolia. Biosci. Microbiota Food Health 2014, 33, 53–64. [Google Scholar] [CrossRef]
- Sun, Z.; Liu, W.; Bao, Q.; Zhang, J.; Hou, Q.; Kwok, L.; Sun, T.; Zhang, H. Investigation of bacterial and fungal diversity in tarag using high-throughput sequencing. J. Dairy Sci. 2014, 97, 6085–6096. [Google Scholar] [CrossRef]
- Xue, J.; Yang, Y.; Wang, Z.; Guo, Y.; Shao, Y. Bacterial Diversity in Chinese Rushan Cheese from Different Geographical Origins. Front. Microbiol. 2018, 9, 1920. [Google Scholar] [CrossRef]
- Mei, J.; Guo, Q.; Wu, Y.; Li, Y. Microbial Diversity of a Camembert-Type Cheese Using Freeze-Dried Tibetan Kefir Coculture as Starter Culture by Culture-Dependent and Culture-Independent Methods. PLoS ONE 2014, 9, e111648. [Google Scholar] [CrossRef]
- Sayevand, H.R.; Bakhtiary, F.; Pointner, A.; Remely, M.; Hippe, B.; Hosseini, H.; Haslberger, A. Bacterial Diversity in Traditional Doogh in Comparison to Industrial Doogh. Curr. Microbiol. 2018, 75, 386–393. [Google Scholar] [CrossRef]
- Mukai, T.; Onose, Y.; Toba, T.; Itoh, T. Presence of glycerol teichoic acid in the cell wall of Lactobacillus kefiranofaciens. Lett. Appl. Microbiol. 1992, 15, 29–31. [Google Scholar] [CrossRef]
- Mukai, T.; Toba, T.; Itoh, T.; Adachi, S. Structural investigation of the capsular polysaccharide from Lactobacillus kefranofaciens K1. Carbohydr. Res. 1990, 204, 227–232. [Google Scholar] [CrossRef]
- Tada, S.; Katakura, Y.; Ninomiya, K.; Shioya, S. Fed-batch coculture of Lactobacillus kefiranofaciens with Saccharomyces cerevisiae for effective production of kefiran. J. Biosci. Bioeng. 2007, 103, 557–562. [Google Scholar] [CrossRef] [PubMed]
- Yokoi, H.; Watanabe, T. Optimum culture conditions for production of kefiran by Lactobacillus sp. KPB-167B isolated from kefir grains. J. Ferment. Bioeng. 1992, 74, 327–329. [Google Scholar] [CrossRef]
- Wang, M.; Bi, J. Modification of characteristics of kefiran by changing the carbon source of Lactobacillus kefiranofaciens. J. Sci. Food Agric. 2008, 88, 763–769. [Google Scholar] [CrossRef]
- Dailin, D.J.; Elsayed, E.A.; Othman, N.Z.; Malek, R.A.; Phin, H.S.; Aziz, R.; Wadaan, M.A.; El-Enshasy, H.A. Bioprocess development for kefiran production by Lactobacillus kefiranofaciens in semi industrial scale bioreactor. Saudi J. Biol. Sci. 2016, 23, 495–502. [Google Scholar] [CrossRef] [PubMed]
- Otles, S.; Cagindi, O. Kefir: A probiotic dairy-composition, nutritional and therapeutic aspects. Pak. J. Nutr. 2003, 2, 54–59. [Google Scholar] [CrossRef]
- Piermaria, J.A.; Pinotti, A.; Garcia, M.A.; Abraham, A.G. Films based on kefiran, an expopolysaccharide obtained from kefir grain: Development and characterization. Food Hydrocoll. 2009, 23, 684–690. [Google Scholar] [CrossRef]
- Zajsek, K.; Kolar, M.; Gorsek, A. Characterisation of the exopolysaccharide kefiran produced by lactic acid bacteria entrapped within natural kefir grains. Int. J. Dairy Technol. 2011, 64, 544–548. [Google Scholar] [CrossRef]
- Cheirsilp, B.; Shoji, H.; Shimizu, H.; Shioya, S. Interactions between Lactobacillus kefiranofaciens and Saccharomyces cerevisiae in mixed culture for kefiran production. J. Biosci. Bioeng. 2003, 96, 279–284. [Google Scholar] [CrossRef]
- Mitsue, T.; Tachibana, K.; Fujio, Y. Efficient kefiran production by a mixed culture of Lactobacillus kefiranofaciens KF- 75 and yeast strains. J. Biosci. Bioeng. 1999, 87, 400. [Google Scholar] [CrossRef]
- Maeda, H.; Zhu, X.; Mitsuoka, T. New Medium for the Production of Exopolysaccharide (OSKC) by Lactobacillus kefiranofaciens. Biosci. Microflora 2003, 22, 45–50. [Google Scholar] [CrossRef]
- Frengova, G.I.; Simova, E.D.; Beshkova, D.M.; Simov, Z.I. Exopolysaccharides Produced by Lactic Acid Bacteria of Kefir Grains. Z. Naturforschung. 2002, 57, 805–810. [Google Scholar] [CrossRef] [PubMed]
- Yokoi, H.; Watanabe, T.; Fuji, Y.; Toba, T.; Adachi, S. Isolation and Characterization of Polysaccharide-Producing Bacteria from Kefir Grains. J. Dairy Sci. 1990, 73, 1684–1689. [Google Scholar] [CrossRef]
- Pop, C.R.; Salanţă, L.; Rotar, A.M.; Semeniuc, C.A.; Socaciu, C.; Sindic, M. Influence of extraction conditions on characteristics of microbial polysaccharide kefiran isolated from kefir grains biomass. J. Food Nutr. Res. 2016, 55, 121–130. [Google Scholar]
- Kooiman, P. The chemical structure of kefiran, the water-soluble polysaccharide of the kefir grain. Carbohydr. Res. 1968, 7, 200–211. [Google Scholar] [CrossRef]
- Micheli, L.; Uccelletti, D.; Palleschi, C.; Crescenzi, V. Isolation and characterisation of a ropy Lactobacillus strain producing the exopolysaccharide kefiran. Appl. Microbiol. Biotechnol. 1999, 53, 69–74. [Google Scholar] [CrossRef]
- Mukai, T.; Toba, T.; Itoh, T.; Adachi, S. Structural microheterogeneity of kefiran from kefir grain. Jpn. J. Zootech. Sci. 1988, 59, 167–176. [Google Scholar] [CrossRef][Green Version]
- Ghasemlou, M.; Khodaiyan, F.; Jahanbin, K.; Gharibzahedi, S.M.T.; Taheri, S. Structural investigation and response surface optimisation for improvement of kefiran production yield from a low-cost culture medium. Food Chem. 2012, 133, 383–389. [Google Scholar] [CrossRef]
- Moradi, Z.; Kalanpour, N. Kefiran, a branched polysaccharide: Preparation, Properties and Applications: A Review. Carbohydr. Polym. 2019, 223, 115100. [Google Scholar] [CrossRef]
- Serafini, F.; Turroni, P.; Ruas-Madiedo, G.A.; Lugli, C.; Milani, S.; Duranti, N.; Zamboni, N.; Bottacini, F.; van Sinderen, D.; Margolles, A.; et al. Kefir fermented milk and kefiran promote growth of Bifidobacterium bifidum PRL2010 and modulate its gene expression. Int. J. Food Microbiol. 2014, 178, 50–59. [Google Scholar] [CrossRef] [PubMed]
- Wang, J.; Tang, W.; Zheng, Y.; Xing, Z.; Wang, Y. Functional and bioinformatics analysis of an exopolysaccharide-related gene (epsN) from Lactobacillus kefiranofaciens ZW3. Arch. Microbiol. 2016, 198, 611–618. [Google Scholar] [CrossRef] [PubMed]
- Xing, Z.; Geng, W.; Li, C.; Sun, Y.; Wang, Y. Comparative genomics of Lactobacillus kefiranofaciens ZW3 and related members of Lactobacillus. spp reveal adaptations to dairy and gut environments. Sci. Rep. 2017, 7, 12827. [Google Scholar] [CrossRef] [PubMed]
- Rimada, P.S.; Abraham, A.G. Kefiran improves rheological properties of glucono-δ-lactone induced skim milk gels. Int. Dairy J. 2006, 16, 33–39. [Google Scholar] [CrossRef]
- Tan, K.X.; Chamundeswari, V.N.; Loo, S.C.J. Prospects of kefiran as a food-derived biopolymer for agri-food and biomedical applications. RSC Adv. 2020, 10, 25339–25351. [Google Scholar] [CrossRef]
- Campedelli, I.; Mathur, H.; Salvetti, E.; Clarke, S.; Rea, M.C.; Torriani, S.; Ross, R.P.; Hill, C.; O’Toole, P.W. Genus-wide assessment of antibiotic resistance in Lactobacillus spp. Appl. Environ. Microbiol. 2018, 85, e01738-18. [Google Scholar] [CrossRef]
- Chen, M.-J.; Tang, H.-Y.; Chiang, M.-L. Effects of heat, cold, acid and bile salt adaptations on the stress tolerance and protein expression of kefir-isolated probiotic Lactobacillus kefiranofaciens M1. Food Microbiol. 2017, 66, 20–27. [Google Scholar] [CrossRef]
- Owaga, E.E.; Chen, M.J.; Chen, W.Y.; Chen, C.W.; Hsieh, R.H. Oral toxicity evaluation of kefir-isolated Lactobacillus kefiranofaciens M1 in sprague-dawley rats. Food Chem. Toxicol. 2014, 70, 157–162. [Google Scholar] [CrossRef]
- Lin, Y.C.; Chen, Y.T.; Li, K.Y.; Chen, M.J. Investigating the Mechanistic Differences of Obesity-Inducing Lactobacillus kefiranofaciens M1 and Anti-obesity Lactobacillus mali APS1 by Microbolomics and Metabolomics. Front. Microbiol. 2020, 11, 1454. [Google Scholar] [CrossRef]
- Jeong, D.; Kim, D.H.; Kang, I.B.; Kim, H.; Song, K.Y.; Kim, H.S.; Seo, K.H. Modulation of gut microbiota and increase in fecal water content in mice induced by administration of Lactobacillus kefiranofaciens DN1. Food Funct. 2017, 8, 680–686. [Google Scholar] [CrossRef]
- Pilote, D. Optimisation des Conditions de Fermentation de la Souche ES R2C2 pour la Valorisation du Lactosérum. Ph.D. Thesis, Université du Québec, INRS Institut Armand-Frappier, Laval, QC, Canada, 2002. [Google Scholar]
- Simard, E.; Pilote, D.; Dupont, C.; Lajoie, N.; Paquet, M.; Lemieux, P.; Goyette, P. Malleable Protein Matrix and Uses Thereof. Patent WO/2003/053158, 8 April 2004. [Google Scholar]
- Berthold, H.K.; Schulte, D.M.; Lapointe, J.-F.; Lemieux, P.; Krone, W.; Gouni-Berthold, I. The whey fermentation product malleable protein matrix decreases triglyceride concentrations in subjects with hypercholesterolemia: A randomized placebo-controlled trial. J. Dairy Sci. 2011, 94, 589–601. [Google Scholar] [CrossRef]
- Farag, M.A.; Jomaa, S.A.; Abd El-Wahed, A.; El-Seedi, H.R. The Many Faces of Kefir Fermented Dairy Products: Quality Characteristics, Flavour Chemistry, Nutritional Value, Health Benefits, and Safety. Nutrients 2020, 12, 346. [Google Scholar] [CrossRef] [PubMed]
- Diniz Rosa, D.; Gouveia Peluzio Mdo, C.; Pérez Bueno, T.; Vega Cañizares, E.; Sánchez Miranda, L.; Mancebo Dorbignyi, B.; Chong Dubí, D.; Espinosa Castaño, I.; Marcin Grzes Kowiak, L.; Fortes Ferreira, C.L. Evaluation of the subchronic toxicity of kefir by oral administration in Wistar rats. Nutr. Hosp. 2014, 29, 1352–1359. [Google Scholar] [CrossRef]
- Batista, L.L.; Malta, S.M.; Guerra Silva, H.C.; Borges, L.D.F.; Rocha, L.O.; da Silva, J.R.; Rodrigues, T.S.; Venturini, G.; Padilha, K.; da Costa Pereira, A.; et al. Kefir metabolites in a fly model for Alzheimer’s disease. Sci. Rep. 2021, 11, 11262. [Google Scholar] [CrossRef] [PubMed]
- Slattery, C.; Cotter, P.D.; O’Toole, P.W. Analysis of Health Benefits Conferred by Lactobacillus Species from Kefir. Nutrients 2019, 11, 1252. [Google Scholar] [CrossRef] [PubMed]
- Biadała, A.; Szablewsk, T.; Lasik-Kurdyś, M.; Cegielska-Radziejewska, R. Antimicrobial activity of goat’s milk fermented by single strain of kefir grain microflora. Eur. Food Res. Technol. 2020, 246, 1231–1239. [Google Scholar] [CrossRef]
- Santos, A.; San Mauro, M.; Sanchez, A.; Torres, J.M.; Marquina, D. The antimicrobial properties of different strains of Lactobacillus spp. isolated from kefir. Syst. Appl. Microbiol. 2003, 26, 434–437. [Google Scholar] [CrossRef] [PubMed]
- Chen, Y.P.; Lee, T.Y.; Hong, W.S.; Hsieh, H.H.; Chen, M.J. Effects of Lactobacillus kefiranofaciens M1 isolated from kefir grains on enterohemorrhagic Escherichia coli infection using mouse and intestinal cell models. J. Dairy Sci. 2013, 96, 7467–7477. [Google Scholar] [CrossRef]
- Bae, D.; Kim, D.H.; Chon, J.W.; Song, K.Y.; Seo, K.H. Synergistic effects of the early administration of Lactobacillus kefiranofaciens DN1 and Kluyveromyces marxianus KU140723-05 on the inhibition of Salmonella Enteritidis colonization in young chickens. Poult. Sci. 2020, 99, 5999–6006. [Google Scholar] [CrossRef]
- Jeong, D.; Kim, D.H.; Kang, I.B.; Kim, H.; Song, K.Y.; Kim, H.-S.; Seo, K.H. Characterization and antibacterial activity of a novel exopolysaccharide produced by Lactobacillus kefiranofaciens DN1 isolated from kefir. Food Control 2017, 78, 436–442. [Google Scholar] [CrossRef]
- Jeong, D.; Kim, D.H.; Song, K.Y.; Seo, K.H. Antimicrobial and anti-biofilm activities of Lactobacillus kefiranofaciens DD2 against oral pathogens. J. Oral Microbiol. 2018, 10, 1472985. [Google Scholar] [CrossRef]
- Hong, W.S.; Chen, H.C.; Chen, Y.P.; Chen, M.J. Effects of kefir supernatant and lactic acid bacteria isolated from kefir grain on cytokine production by macrophage. Int. Dairy J. 2009, 19, 244–251. [Google Scholar] [CrossRef]
- Hong, W.S.; Chen, Y.P.; Chen, M.J. The Antiallergic Effect of Kefir Lactobacilli. J. Food Sci. 2010, 75, H244–H253. [Google Scholar] [CrossRef] [PubMed]
- Hong, W.S.; Chen, Y.P.; Dai, T.Y.; Huang, I.N.; Chen, M.J. Effect of Heat-Inactivated Kefir-Isolated Lactobacillus kefiranofaciens M1 on Preventing an Allergic Airway Response in Mice. J. Agric. Food Chem. 2011, 59, 9022–9031. [Google Scholar] [CrossRef] [PubMed]
- Chen, Y.P.; Hsiao, P.J.; Hong, W.S.; Dai, T.Y.; Chen, M.J. Lactobacillus kefiranofaciens M1 isolated from milk kefir grains ameliorates experimental colitis in vitro and in vivo. J. Dairy Sci. 2012, 95, 63–74. [Google Scholar] [CrossRef] [PubMed]
- Chen, Y.P.; Chen, M.J. Effects of Lactobacillus kefiranofaciens M1 isolated from kefir grains on germ-free mice. PLoS ONE 2013, 8, e78789. [Google Scholar] [CrossRef] [PubMed]
- Xing, Z.; Tang, W.; Yang, Y.; Geng, W.; Rehman, R.U.; Wang, Y. Colonization and Gut Flora Modulation of Lactobacillus kefiranofaciens ZW3 in the Intestinal Tract of Mice. Probiotics Antimicrob. Proteins 2017, 10, 374–382. [Google Scholar] [CrossRef]
- Seo, M.K.; Park, E.J.; Ko, S.Y.; Choi, E.W.; Kim, S. Therapeutic effects of kefir grain Lactobacillus-derived extracellular vesicles in mice with 2,4,6-trinitrobenzene sulfonic acid-induced inflammatory bowel disease. J. Dairy Sci. 2018, 101, 8662–8671. [Google Scholar] [CrossRef]
- Lin, Y.-C.; Chen, Y.-T.; Hsieh, H.-H.; Chen, M.-J. Effect of Lactobacillus mali APS1 and L. kefiranofaciens M1 on obesity and glucose homeostasis in diet-induced obese mice. J. Funct. Foods. 2016, 23, 580–589. [Google Scholar] [CrossRef]
- Wei, S.; Chen, Y.; Chen, M. Selecting probiotics with the abilities of enhancing GLP-1 to mitigate the progression of type 1 diabetes in vitro and in vivo. J. Funct. Foods. 2015, 18, 473–486. [Google Scholar] [CrossRef]
- Friques, A.G.F.; Arpini, C.M.; Kalil, I.C.; Gava, A.L.; Leal, M.A.; Porto, M.L.; Vasquez, E.C.; Nogueira, B.V.; Dias, A.T.; Andrade, T.U.; et al. Chronic administration of the probiotic kefir improves the endothelial function in spontaneously hypertensive rats. J. Transl. Med. 2015, 13, 390. [Google Scholar] [CrossRef] [PubMed]
- Xing, Z.; Tang, W.; Geng, W.; Zheng, Y.; Wang, Y. In Vitro and in vivo evaluation of the probiotic attributes of Lactobacillus kefiranofaciens XL10 isolated from Tibetan kefir grain. Appl. Microbiol. Biotechnol. 2017, 101, 2467–2477. [Google Scholar] [CrossRef] [PubMed]
- Sun, Y.; Geng, W.; Pan, Y.; Wang, J.; Xiao, P.; Wang, Y. Supplementation with Lactobacillus kefiranofaciens ZW3 from Tibetan Kefir improves depression-like behavior in stressed mice by modulating the gut microbiota. Food Funct. 2019, 20, 925–937. [Google Scholar] [CrossRef]
- Oryan, A.; Alemzadeh, E.; Eskandari, M.H. Kefir Accelerates Burn Wound Healing Through Inducing Fibroblast Cell Migration In Vitro and Modulating the Expression of IL-1ß, TGF-ß1, and bFGF Genes In Vivo. Probiotics Antimicrob. Proteins 2019, 11, 874–886. [Google Scholar] [CrossRef] [PubMed]
- Beaulieu, J.; Dubuc, R.; Beaudet, N.; Dupont, C.; Lemieux, P. Immunomodulation by a malleable matrix composed of fermented whey proteins and lactic acid bacteria. J. Med. Food. 2007, 10, 67–72. [Google Scholar] [CrossRef]
- Beaulieu, J.; Dupont, C.; Lemieux, P. Anti-inflammatory potential of a malleable matrix composed of fermented whey proteins and lactic acid bacteria in an atopic dermatitis model. J. Inflamm. 2007, 4, 6. [Google Scholar] [CrossRef]
- Beaulieu, J.; Girard, D.; Dupont, C.; Lemieux, P. Inhibition of neutrophil infiltration by a malleable protein matrix of lactic acid bacteria-fermented whey proteins in vivo. Inflamm. Res. 2009, 58, 133–138. [Google Scholar] [CrossRef]
- Beaulieu, J.; Millette, E.; Trottier, E.; Précourt, L.-P.; Dupont, C.; Lemieux, P. Regulatory Function of a Malleable Protein Matrix as a Novel Fermented Whey Product on Features Defining the Metabolic Syndrome. J. Med. Food. 2010, 13, 509–519. [Google Scholar] [CrossRef]
- Ghasemlou, M.; Khodaiyan, F.; Oromiehie, A.; Yarmand, M.S. Development and characterisation of a new biodegradable edible film made from kefiran, an exopolysaccharide obtained from kefir grains. Food Chem. 2011, 127, 1496–1502. [Google Scholar] [CrossRef]
- Rodrigues, K.L.; Caputo, L.R.G.; Carvalho, J.C.T.; Evangelista, J.; Schneedorf, J.M. Antimicrobial and healing activity of kefir and kefiran extract. Int. J. Antimicrob. Agents 2005, 25, 404–408. [Google Scholar] [CrossRef]
- Blandón, L.M.; Noseda, M.D.; Islan, G.A.; Castro, G.R.; de Melo Pereira, G.V.; Thomaz-Soccol, V.; Soccol, C.R. Optimization of culture conditions for kefiran production in whey: The structural and biocidal properties of the resulting polysaccharide. Bioact. Carbohydr. Diet. Fibre 2018, 16, 14–21. [Google Scholar] [CrossRef]
- Barbosa, A.F.; Santos, P.G.; Lucho, A.M.S.; Schneedorf, J.M. Kefiran can disrupt the cell membrane through induced pore formation. J. Electroanal. Chem. 2011, 653, 61–66. [Google Scholar] [CrossRef]
- Medrano, M.; Hamet, M.F.; Abraham, A.G.; Pérez, P.F. Kefiran protects Caco-2 cells from cytopathic effects induced by Bacillus cereus infection. Anton. Leeuw. 2009, 96, 505–513. [Google Scholar] [CrossRef] [PubMed]
- Furuno, T.; Nakanishi, M. Kefiran suppresses antigen-induced mast cell activation. Biol. Pharm. Bull. 2012, 35, 178–183. [Google Scholar] [CrossRef] [PubMed]
- Vinderola, G.; Perdigón, G.; Duarte, J.; Farnworth, E.; Matar, C. Effects of the oral administration of the exopolysaccharide produced by Lactobacillus kefiranofaciens on the gut mucosal immunity. Cytokine 2006, 36, 254–260. [Google Scholar] [CrossRef] [PubMed]
- Medrano, M.; Racedo, S.M.; Rolny, I.S.; Abraham, A.G.; Pérez, P.F. Oral Administration of Kefiran Induces Changes in the Balance of Immune Cells in a Murine Model. J. Agric. Food Chem. 2011, 59, 5299–5304. [Google Scholar] [CrossRef]
- Rodrigues, K.L.; Carvalho, J.C.T.; Schneedorf, J.M. Anti-inflammatory properties of kefir and its polysaccharide extract. Inflammopharmacology 2005, 13, 485–492. [Google Scholar] [CrossRef]
- Maeda, H.; Zhu, X.; Omura, K.; Suzuki, S.; Kitamura, S. Effects of an exopolysaccharide (kefiran) on lipids, blood pressure, blood glucose, and constipation. BioFactors 2004, 22, 197–200. [Google Scholar] [CrossRef]
- Maeda, H.; Mizumoto, H.; Suzuki, M.; Tsuji, K. Effects of Kefiran-Feeding on Fecal Cholesterol Excretion, Hepatic Injury and Intestinal Histamine Concentration in Rats. Biosci. Microflora 2005, 24, 35–40. [Google Scholar] [CrossRef]
- Kwon, O.-K.; Ahn, K.-S.; Lee, M.-Y.; Kim, S.-Y.; Park, B.-Y.; Kim, M.-K.; Lee, I.-Y.; Oh, S.-R.; Lee, H.-K. Inhibitory effect of kefiran on ovalbumin-induced lung inflammation in a murine model of asthma. Arch. Pharm. Res. 2008, 31, 1590–1596. [Google Scholar] [CrossRef]
- Uchida, M.; Ishii, I.; Inoue, C.; Akisato, Y.; Watanabe, K.; Hosoyama, S.; Toida, T.; Ariyoshi, N.; Kitada, M. Kefiran reduces atherosclerosis in rabbits fed a high cholesterol diet. J. Atheroscler. Thromb. 2010, 17, 980–988. [Google Scholar] [CrossRef]
- Shiomi, M.; Sasaki, K.; Murofushi, M.; Aibara, K. Antitumor activity in mice of orally administered polysaccharide from kefir grain. Jpn. J. Med. Sci. Biol. 1982, 35, 75–80. [Google Scholar] [CrossRef]
- Elsayed, E.A.; Farooq, M.; Dailin, D.; El-Enshasy, H.A.; Othman, N.Z.; Malek, R.; Danial, E.; Wadaan, M. In vitro and in vivo biological screening of kefiran polysaccharide produced by Lactobacillus kefiranofaciens. Biomed. Res. 2017, 28, 594–600. [Google Scholar]
- Hamet, M.F.; Medrano, M.; Pérez, P.F.; Abraham, A.G. Oral administration of kefiran exerts a bifidogenic effect on BALB/c mice intestinal microbiota. Benef. Microbes 2016, 7, 237–246. [Google Scholar] [CrossRef]
- Sugawara, T.; Furuhashi, T.; Shibata, K.; Abe, M.; Kikuchi, K.; Arai, M.; Sakamoto, K. Fermented product of rice with Lactobacillus kefiranofaciens induces anti-aging effects and heat stress tolerance in nematodes via DAF-16. Biosci. Biotechnol. Biochem. 2019, 83, 1484–1489. [Google Scholar] [CrossRef]
- Toscano, M.; Carfi Pavia, F.; Conoscenti, G.; Sabatino, M.; La Carrubba, V.; Dispenza, C.; Brucato, V. Kefiran-based Scaffolds for Biomedical Applications. Chem. Eng. Trans. 2018, 64, 181–186. [Google Scholar] [CrossRef]
- Shahbandeh, M. Size of the Kefir Market Worldwide from 2018 to 2023. Available online: https://www.statista.com/statistics/958465/kefir-market-size-worldwide/ (accessed on 18 January 2019).
- Esener, O.; Balkan, B.; Armutak, E.; Uvez, A.; Yildiz, G.; Hafizoglu, M.; Yilmazer, N.; Gurel-Gurevin, E. Donkey milk kefir induces apoptosis and suppresses proliferation of Ehrlich ascites carcinoma by decreasing iNOS in mice. Biotech. Histochem. 2018, 93, 424–431. [Google Scholar] [CrossRef] [PubMed]
- Prado, M.R.; Blandón, L.M.; Vandenberghe, L.P.S.; Rodrigues, C.; Castro, G.R.; Thomaz-Soccol, V.; Soccol, C.R. Milk kefir: Composition, microbial cultures, biological activities, and related products. Front. Microbiol. 2015, 6, 1177. [Google Scholar] [CrossRef]
- Farnworth, E.R.; Mainville, I. Kefir: A fermented milk product. In Handbook of Fermented Functional Foods, 1st ed.; Farnworth, E.R., Ed.; CRC Press: London, UK, 2003; pp. 77–112. [Google Scholar]
- Chen, T.-H.; Wang, S.-Y.; Chen, K.-N.; Liu, J.-R.; Chen, M.-J. Microbiological and chemical properties of kefir manufactured by entrapped microorganisms isolated from kefir grains. J. Dairy Sci. 2009, 92, 3002–3013. [Google Scholar] [CrossRef] [PubMed]
- Assadi, M.; Pourahmad, R.; Moazami, N. Use of isolated kefir starter cultures in kefir production. World J. Microbiol. Biotechnol. 2000, 16, 541–543. [Google Scholar] [CrossRef]
- Gao, X.; Li, B. Chemical and microbiological characteristics of kefir grains and their fermented dairy products: A review. Cogent Food Agric. 2016, 2, 1272152. [Google Scholar] [CrossRef]
- Katechaki, E.; Panas, P.; Kourkoutas, Y.; Koliopoulos, D.; Koutinas, A.A. Thermally-dried free and immobilized kefir cells as starter culture in hard-type cheese production. Bioresour. Technol. 2009, 100, 3618–3624. [Google Scholar] [CrossRef] [PubMed]
- Dimitrellou, D.; Kandylis, P.; Mallouchos, A.; Komaitis, M.; Koutinas, A.A.; Kourkoutas, Y. Effect of freeze–dried kefir culture on proteolysis in feta-type and whey-cheeses. Food Chem. 2010, 119, 795–800. [Google Scholar] [CrossRef]
- Rehman, R.U.; Wang, Y.; Wang, J.; Geng, W. A microbiological study of Mozzarella cheese made by Lactobacillus kefiranofaciens ZW3 throughout cheese making and ripening. J. Biol. Environ. Sci. 2017, 11, 187–193. [Google Scholar]
- Ng, K.S.; Wang, S.-Y.; Chen, M.J. A novel immobilized cell system involving Taiwanese kefir microorganisms and sugar cane pieces for fermented milk production. J. Dairy Sci. 2020, 103, 141–149. [Google Scholar] [CrossRef] [PubMed]

| PCR Type | Primer/Probe | Sequence (5′-3′) | Reference |
|---|---|---|---|
| Species-specific PCR | Forward (R2C2-16SF) | TAAGAAAGCA GTTCGCATGA ACAG | [20] Patent US 2009/0130.072 A1 |
| Reverse (R2C2-16SR) | GGGACTTTGT ATCTCTACAA ATGG | ||
| Real-time PCR | Forward | CAGTTCGCATGAACAGCTTTTAA | [37] |
| Reverse | GCACCGCGGGTCCAT | ||
| Probe | FAM-CGCAAGCTGTCGCTAA-TAMRA | ||
| Colony species-specific PCR, qPCR | Forward (LK1-2F) | GAGCGGAACCAGCAGAATCA | [28] |
| Reverse (LK1-2R) | GCTGTTCATGCGAACTGCTT | ||
| Probe | FITH-CCACCGCTACACATGGAGTTCTAC | ||
| Multiplexed qPCR | Forward | GCAACAACCAAAGTATTGTA | [38] |
| Reverse | TAGCCGAAGAGGATCTAA | ||
| Probe | Q705-ACC[+A]CA[+T]CA[+C]CA[+A]CTCTAA-BHQ3 |
| Origin | Detection | Number of Isolates | Reference |
|---|---|---|---|
| Grains, Denmark | CD | Ropy colonies | [12] |
| Grains, Denmark | CD | 4 of the above colonies | [3] |
| Grains, Denmark | CD | 26 | [39] |
| Grains, France, Denmark, Canada | CD | 14 previously isolated | [10] |
| Grains, Russia | CD | 3 | [18] |
| Grains, Belgium | CI | - | [49] |
| Grains, Taiwan | CD, CI | 3 | [26] |
| Grains, China | CD | Ropy colonies | [21] |
| Grains, China | CI | - | [45] |
| Grains and beverages, Brazil | CI | - | [47] |
| Grains and beverages, Ireland | CI | - | [31] |
| Grains and beverages, Turkey | CD, CI | Not detected | [29] |
| Grains, Turkey | CI | - | [55] |
| Grains, Brazil | CI | - | [46] |
| Grains, Slovenia | CD, CI | 40 | [48] |
| Grains, Argentina | CD, CI | 11 | [27] |
| Grains, Turkey | CI | - | [51] |
| Grains, China | CD, CI | 11 | [44] |
| Grains, Italy | CD, CI | - | [23] |
| Grains, Korea | CI | - | [37] |
| Grains, Belgium | CI | - | [50] |
| Grains, Brazil | CD, CI | 5 | [22] |
| Grains, USA | CI | - | [56] |
| Grains, Russia | CD, CI | Not detected | [30] |
| Grains and beverages, Ireland, France, United Kingdom | CI | - | [34] |
| Grains, Malaysia | CI | - | [57] |
| Grains, Turkey | CI | - | [35] |
| Grains, China | CD, CI | 18 | [28] |
| Kefir and beverages, China | CI | - | [58] |
| Beverages, Korea | CI | - | [59] |
| Grains, China | CI | - | [60] |
| Grains, Turkey | CD | 3 | [61] |
| Grains, Greece | CI | - | [62] |
| Beverage, Korea | CI | - | [63] |
| Grains and beverages, Germany, Italy | CI | - | [38] |
| Grains and beverages, United Kingdom, Caucuses region, Ireland, Lithuania, South Korea, USA | CI | - | [64] |
| Grains, China, Germany, USA | CI | - | [65] |
| Grains, China | CD, CI | 1 | [66] |
Publisher’s Note: MDPI stays neutral with regard to jurisdictional claims in published maps and institutional affiliations. |
© 2021 by the authors. Licensee MDPI, Basel, Switzerland. This article is an open access article distributed under the terms and conditions of the Creative Commons Attribution (CC BY) license (https://creativecommons.org/licenses/by/4.0/).
Share and Cite
Georgalaki, M.; Zoumpopoulou, G.; Anastasiou, R.; Kazou, M.; Tsakalidou, E. Lactobacillus kefiranofaciens: From Isolation and Taxonomy to Probiotic Properties and Applications. Microorganisms 2021, 9, 2158. https://doi.org/10.3390/microorganisms9102158
Georgalaki M, Zoumpopoulou G, Anastasiou R, Kazou M, Tsakalidou E. Lactobacillus kefiranofaciens: From Isolation and Taxonomy to Probiotic Properties and Applications. Microorganisms. 2021; 9(10):2158. https://doi.org/10.3390/microorganisms9102158
Chicago/Turabian StyleGeorgalaki, Marina, Georgia Zoumpopoulou, Rania Anastasiou, Maria Kazou, and Effie Tsakalidou. 2021. "Lactobacillus kefiranofaciens: From Isolation and Taxonomy to Probiotic Properties and Applications" Microorganisms 9, no. 10: 2158. https://doi.org/10.3390/microorganisms9102158
APA StyleGeorgalaki, M., Zoumpopoulou, G., Anastasiou, R., Kazou, M., & Tsakalidou, E. (2021). Lactobacillus kefiranofaciens: From Isolation and Taxonomy to Probiotic Properties and Applications. Microorganisms, 9(10), 2158. https://doi.org/10.3390/microorganisms9102158






